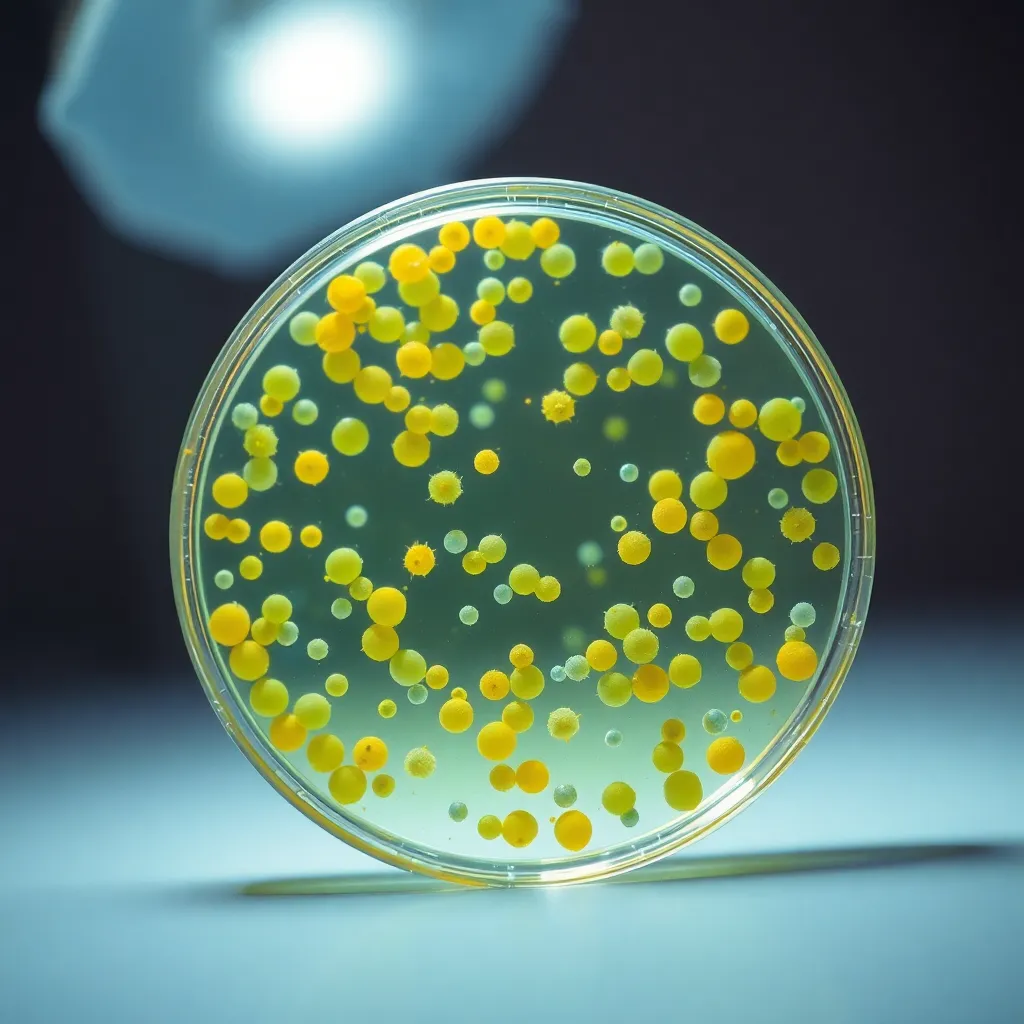
Close-Up of Bacterial Cultures in Petri Dish

Related Tags

Scientist Analyzing Bacteria in Laboratory
Close-Up of Bacterial Cultures in Petri Dish

Petri Dish with Bacterial Cultures

Biologist Examining Bacteria Cultures

Petri Dish with Bacterial Culture in Laboratory

Petri Dish with Bacterial Cultures

Scientist Analyzing Bacterial Cultures

Bacterial Cultures in Studio Setup

Petri Dish with Growing Bacterial Cultures

Bacterial Colonies on Agar Plate

Bacterial Colonies Under Microscope

Vibrant Bacteria Culture on Agar Plate

Bacterial Culture on Agar Plate

Colony Growth on Agar Plate Under Microscope

Microscopic Slide of Bacteria Culture

Vibrant Bacterial Cultures Under Microscope

Lab Technician Analyzing Bacterial Cultures

Bacterial Colonies on Agar Plate

Bacteria Colonies on Agar Gel

Vibrant Bacterial Cultures Under Microscope